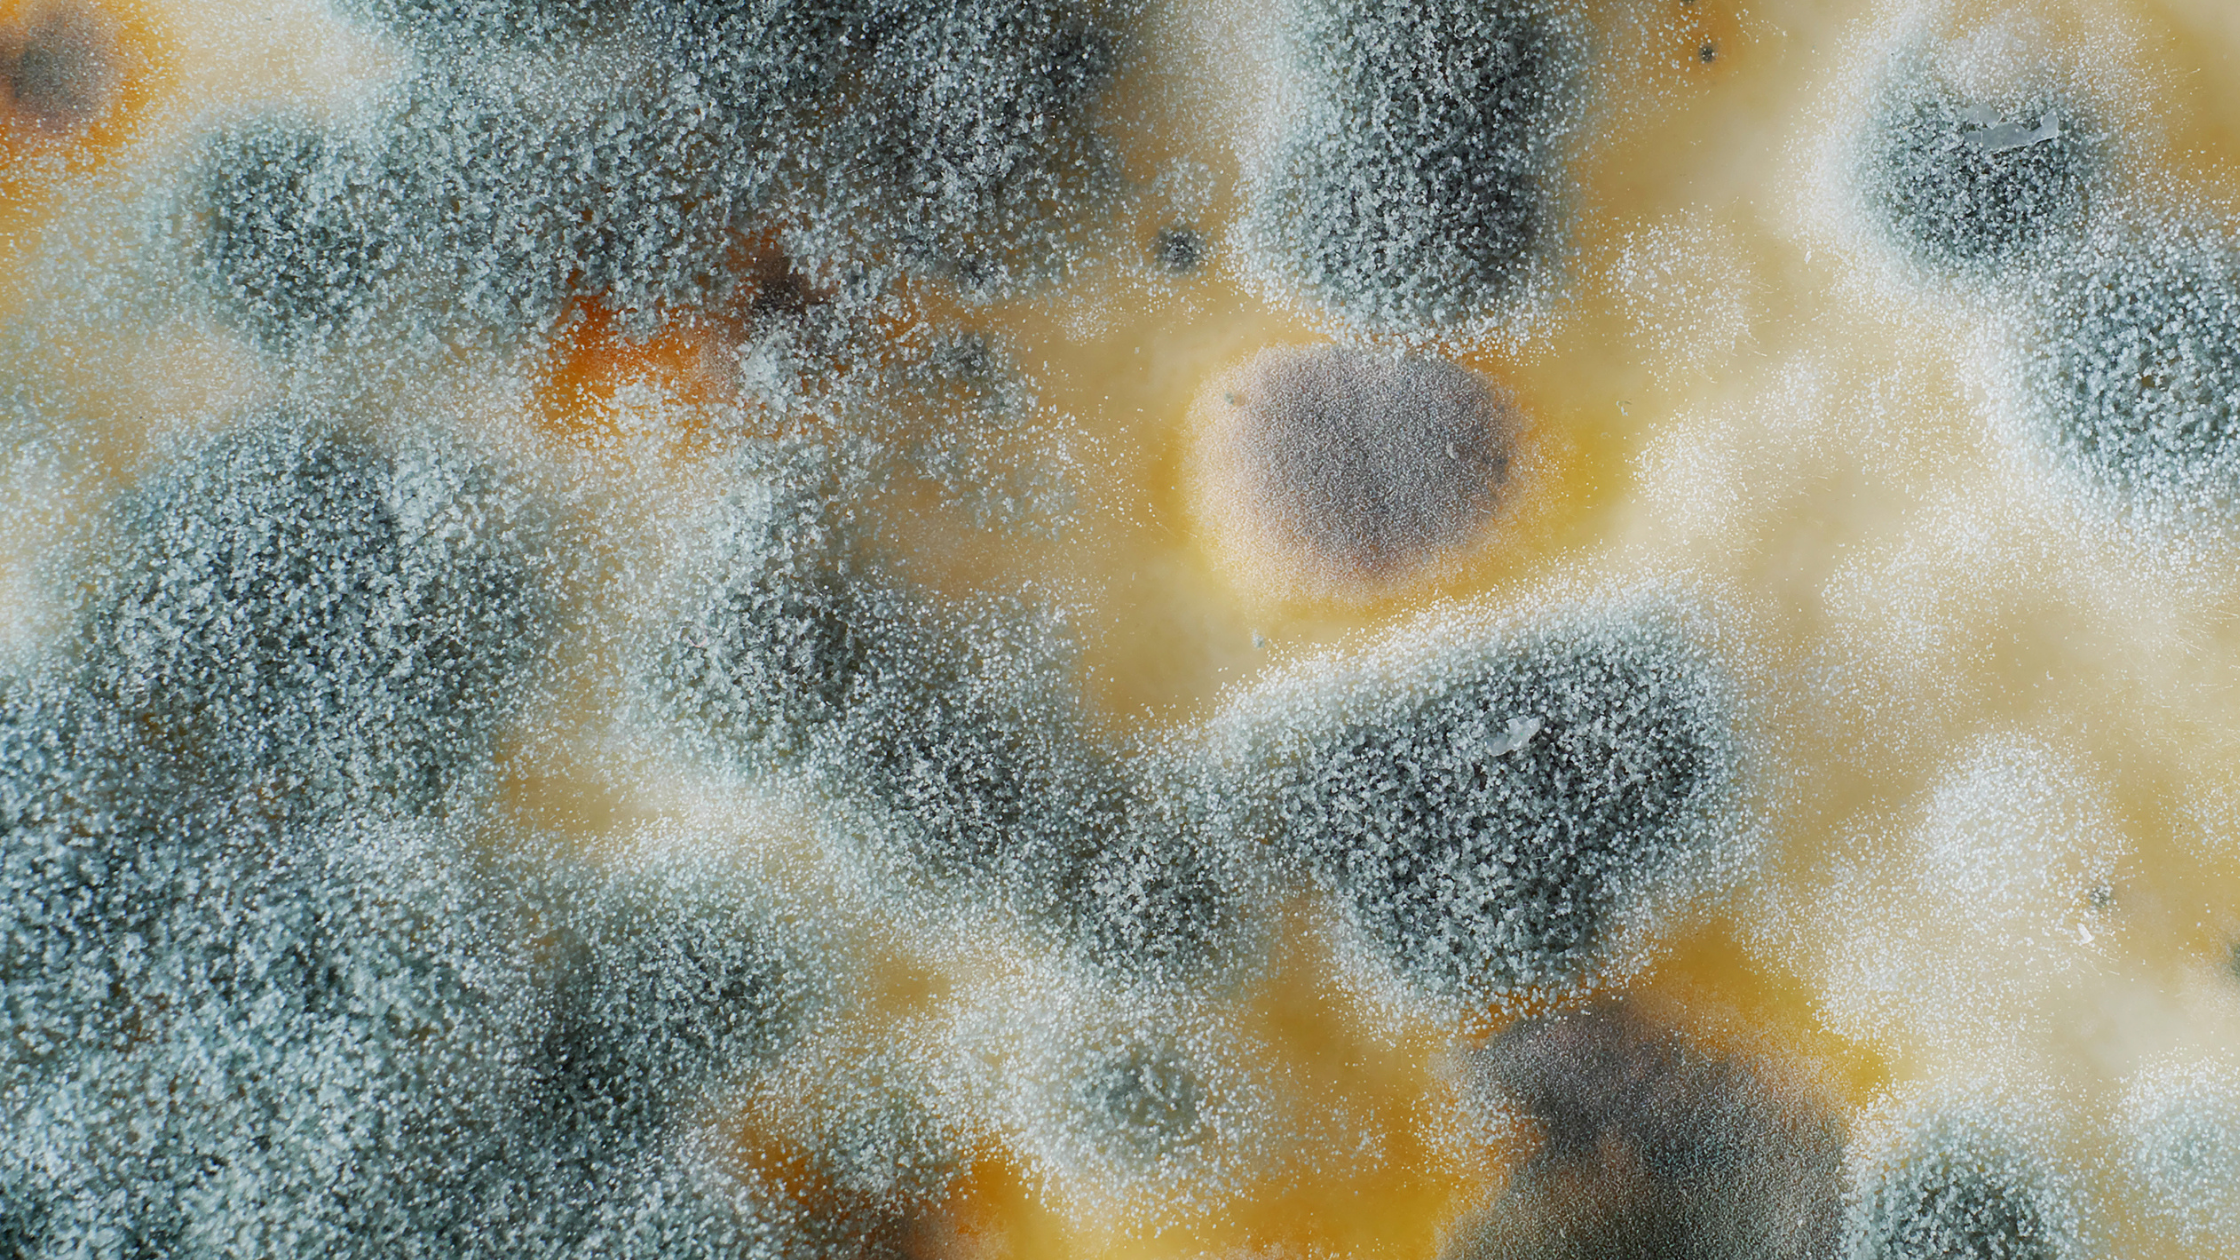

O agricultor e a segurança de alimentos nos dias de hoje
Desde os primórdios da história, o homem cultiva a terra com o objetivo de produzir alimentos para a sua subsistência. Com o passar dos séculos,

Desde os primórdios da história, o homem cultiva a terra com o objetivo de produzir alimentos para a sua subsistência. Com o passar dos séculos,
O termo micotoxina é derivado da palavra grega “mykes” que significa fungo e do latin “toxican” que significa toxinas. Designa um grupo de compostos produzidos

Nos serviços de alimentação, as telas milimétricas devem ser instaladas nas aberturas das áreas de armazenamento e preparação de alimentos para evitar o acesso de

Geralmente associadas a infecções hospitalares e presentes em ambientes de assistência à saúde, algumas espécies de Acinetobacter têm chamado a atenção pela sua presença em
(1).jpeg)
O leite humano possui uma composição nutricional única e balanceada, além de possuir agentes anti-inflamatórios, enzimas digestivas, hormônios e fatores de crescimento (veja figura abaixo).

Depois de 25 anos, a Anvisa publicou a RDC nº 868, de 17 de maio de 2024, com as novas diretrizes básicas para a avaliação

De origem bacteriana, o botulismo é uma doença grave, não contagiosa, causada pela ação de uma potente neurotoxina produzida pela bactéria Clostridium botulinum (C. botulinum),

Dentro das rotinas de um laboratório, certas práticas são essenciais para garantir a produtividade e eficiência necessárias para um desempenho de alta performance. Este artigo

É cada vez maior a busca dos consumidores por alimentos naturais e com redução de aditivos alimentares, como por exemplo, os conservantes sintetizados quimicamente. Entretanto,

A contaminação de alimentos é uma preocupação constante em todos os países do mundo. De acordo com a Anvisa, contaminantes em alimentos são “agentes biológicos, físicos

Apesar de inúmeros benefícios, alguns alimentos possuem fatores antinutricionais (FANs), como metabólitos secundários, que nos alimentos de origem vegetal atuam como mecanismo de defesa contra

A segurança de alimentos é indispensável na indústria alimentícia e um aspecto muitas vezes negligenciado é a escolha adequada de secadores de mãos. Embora possa

Muitos me perguntam como escolhi a área de qualidade. Bom, não foi exatamente uma escolha; foi um momento em que eu estava precisando trabalhar, mas

Muitos me perguntam como mudar a cultura de uma equipe de chão de fábrica e como tornar as metodologias e normas complexas acessíveis no dia

Vocês devem estar acompanhando aqui no Food Safety Brazil as inúmeras novidades que a FSSC 22000 vêm trazendo ultimamente. Uma delas, já tratada aqui, é

A luz UVC é uma tecnologia que já é utilizada há quase um século, por diversos segmentos industriais relacionados à saúde pública e à segurança

A utilização de luvas em serviços de alimentação é um tema polêmico para muitos profissionais. Nutricionistas sabem bem que seu uso deve ser precedido por

Gerir uma grande indústria alimentícia é um desafio constante, que exige foco e determinação para alcançar resultados expressivos. A chave para o sucesso está em

Em todas as empresas que possuíam sistemas de limpeza e sanitização fechados utilizando Clean in Place (CIP), a necessidade de qualificação e validação desses sistemas

Em um passado nada distante, durante a pandemia, vivemos mudanças de comportamentos em nível mundial sob muitos aspectos. Dentre as principais mudanças, destacaram-se o aumento

Muitos questionam se os produtos químicos e os métodos utilizados na limpeza industrial de processos e equipamentos são adequados. Contudo, observa-se que focar apenas nos

“Eu vou tomar um tacacá, dançar, curtir, ficar de boa”, esse é um trecho de uma música que viralizou recentemente da cantora paraense Joelma. Mas

O desconforto térmico nas cozinhas comerciais e institucionais causado pelo excesso de calor pode implicar na qualidade de vida dos funcionários, assim como comprometer a

A nova versão da FSSC 22000 possui um item que aborda a Cultura de Qualidade e Segurança de Alimentos (veja aqui). E como andam as